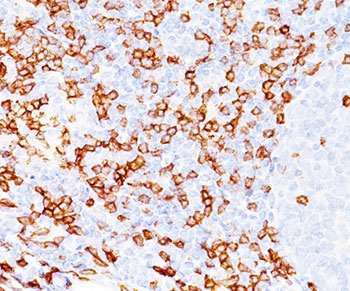
CD8a Antibody

You have no items in your shopping cart.
CD8a protein
SKU: orb315535
Featured
Description
Images & Validation
−Item 1 of 1
| Tested Applications | ELISA, SDS-PAGE, WB |
|---|---|
| Application Notes |
Key Properties
−| Species/Host | E. coli |
|---|---|
| Target | CD8a |
| Reactivity | Human |
| Molecular Weight | 17.0 kDa |
| Protein Sequence | SQFRVSPLDR TWNLGETVEL KCQVLLSNPT SGCSWLFQPR GAAASPTFLL YLSQNKPKAA EGLDTQRFSG KRLGDTFVLT LSDFRRENEG YYFCSALSNS IMYFSHFVPV FLPAKPTTTP A |
| Purity | > 85.0% as determined by 15% SDS-PAGE |
| Conjugation | Unconjugated |
Storage & Handling
−| Storage | Store at 4°C for up to two weeks. For long term storage, aliquot and store at -20°C, avoid freeze/thaw cycles. |
|---|---|
| Form/Appearance | 20mM Tris-HCl, 50mM NaCl, 1M Urea, 1mM DTT pH 7.5 |
| Concentration | 1 mg/ml |
| Expiration Date | 6 months from date of receipt. |
| Disclaimer | For research use only |
Similar Products
−Human CD8A protein [orb358796]
Greater than 90% as determined by SDS-PAGE.
19.6 kDa
Yeast
20 μg, 1 mg, 100 μgHuman CD8A protein [orb358935]
Greater than 90% as determined by SDS-PAGE.
21.6 kDa
Mammalian cell
20 μg, 100 μg, 1 mg

Quality Guarantee
Explore bioreagents carefree to elevate your research. All our products are rigorously tested for performance. If a product does not perform as described on its datasheet, our scientific support team will provide expert troubleshooting, a prompt replacement, or a refund. For full details, please see our Terms & Conditions and Buying Guide. Contact us at [email protected].

SDS-PAGE analysis of CD8a protein
Documents Download
Datasheet
Product Information
Request a Document
Protocol Information
WB
Western Blot (IB, immunoblot)
ELISA
Enzyme-linked Immunosorbent Assay (EIA)
SDS-PAGE
Sodium Dodecyl Sulphate PolyAcrylamide Gel Electrophoresis
CD8a protein (orb315535)
Based on 0 reviews
Participating in our Biorbyt product reviews program enables you to support fellow scientists by sharing your firsthand experience with our products.
Login to Submit a Review